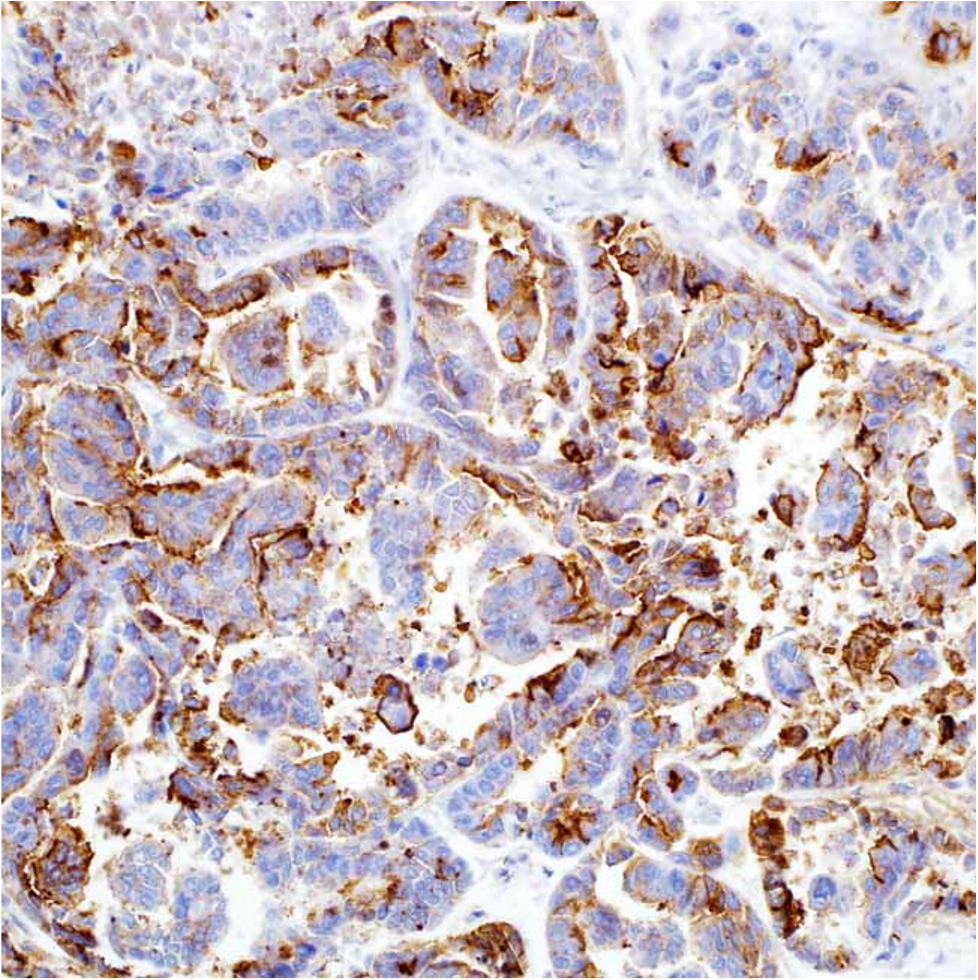
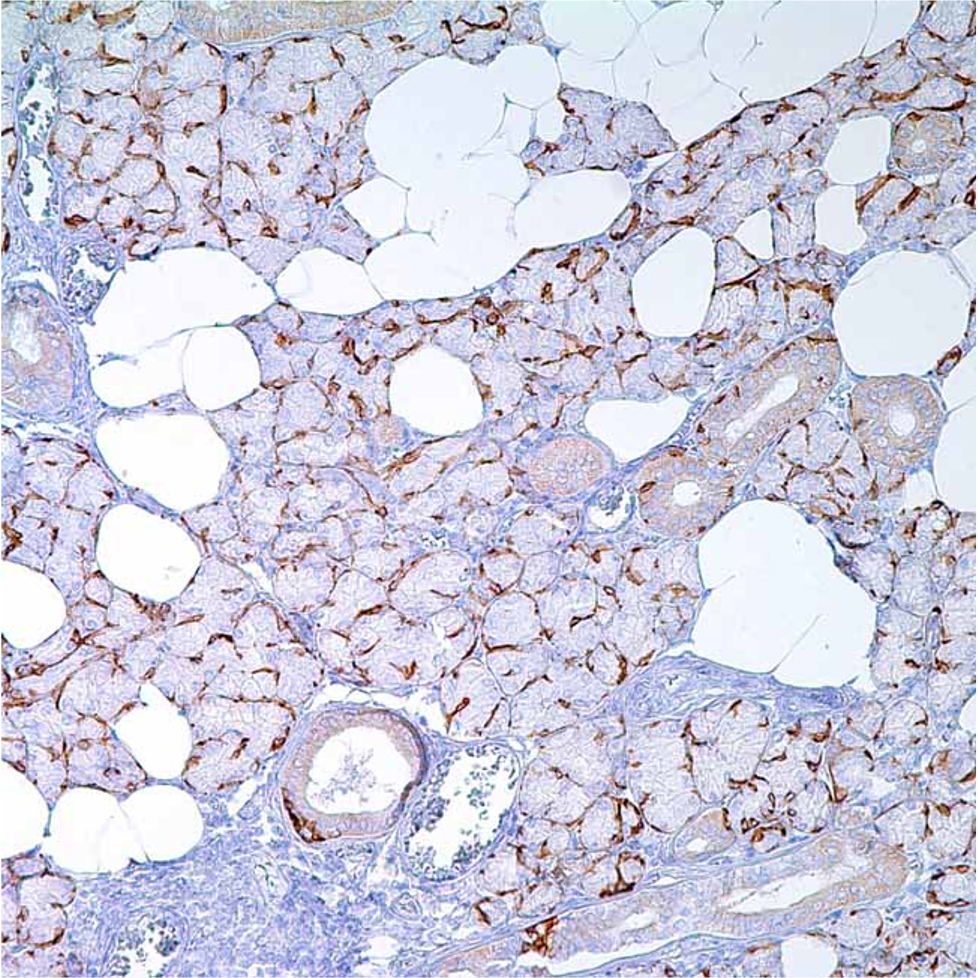

TLE1

TdT

STAT6

GATA3

PRAME

PHOX2B

PAX-8

MDM2

IgG4

IDH1
HBME-1
Cytokeratin 14

CDK4

ATRX

ALK Protein
This division delivers a comprehensive range of diagnostic and research laboratory products, including automated analyzers such as the Samplex TAS101 from Tascom (Korea), high-quality antibodies from Zeta Corporation and Cell Marque, as well as specialized control blocks from Histocytes.
Our solutions support accurate diagnostics, pathology workflows, histopathology applications, and research-driven analysis, ensuring reliability and performance across clinical and laboratory environments.